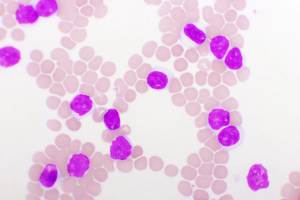

Data from SERENA-6 showed delayed disease progression and deterioration in QOL among patients who switched to camizestrant plus CDK4/6 inhibition.

Your AI-Trained Oncology Knowledge Connection!


Data from SERENA-6 showed delayed disease progression and deterioration in QOL among patients who switched to camizestrant plus CDK4/6 inhibition.

The 6- and 12-month PFS rates were 76.4% and 68.2%, respectively, in patients with relapsed/refractory multiple myeloma who discontinued treatment with teclistamab early.

“HER2CLIMB-05 has demonstrated that the addition of tucatinib to HP represents an enhanced frontline maintenance therapy option for patients with HER2-positive metastatic breast cancer,” said Erika Hamilton, MD.

“Pirtobrutinib continues to show favorable efficacy and promising overall survival [OS],” said William G. Wierda, MD, PhD.

The 24-month RFS rates were 95.1%, 81.2%, 69.4%, and 48.4% in patients with stage III melanoma who experienced a pCR, near pCR, pPR, pNR, respectively.

Phase 2 data showed no dose-limiting toxicities with EIK1001 plus pembrolizumab in patients with advanced non–small cell lung cancer.

Data from the REZILIENT2 trial show meaningful intracranial activity in patients with NSCLC harboring EGFR exon 20 insertions or other uncommon mutations.

Patients with ESCC treated in 2 tislelizumab-based arms experienced higher composite complete response rates compared to chemoradiotherapy alone.

BNT111 combined with cemiplimab showed promising efficacy in treating PD-(L) PD-L1-relapsed/refractory melanoma, achieving an 18.1% objective response rate.

Meta: Safety outcomes, including the treatment-related AEs and AEs leading to treatment discontinuation, were consistent with or without lenvatinib in ESCC.

Daratumumab, lenalidomide, ixazomib, and dexamethasone yielded PFS/OS outcomes in transplant-ineligible, newly diagnosed myeloma.

Zidesamtinib was well tolerated in patients who received prior ROS1 TKI therapy with advanced NSCLC, and dose discontinuation/reduction rates were low.

Efficacy and biomarker analyses from CheckMate-77T support perioperative nivolumab as an effective option in resectable NSCLC.

Camizestrant and continued CDK4/6 inhibition delayed time to QOL deterioration vs SOC therapy in ER+/HER2– advanced breast cancer.

Vepdegestrant shows significant clinical activity and a favorable safety profile in ESR1-mutant HER2-negative, ER-positive metastatic breast cancer vs fulvestrant.

Final OS data from INAVO120 demonstrate, for the first time, a significant OS improvement with a PI3K-targeted agent in this breast cancer population.

A phase 2 study found a complete clinical response of 82% with neoadjuvant dostarlimab in dMMR solid tumors.

Results from the OVARIO trial found HRQOL maintained with niraparib/bevacizumab maintenance in patients with advanced ovarian cancer.

Cadonilimab plus lenvatinib appeared to have a manageable safety profile in a phase 2 trial.

Phase 1/2 SYLT-023 trial evaluated the efficacy and safety of tislelizumab plus chemotherapy in patients with advanced, HER2-negative, mismatch repair–proficient gastric/GEJ cancer.

For patients with hormone receptor-positive and HER2-low breast cancer, T-DXd elicited higher levels of PFS despite time to progression and disease burden.

Phase 3 data support tafasitamab plus lenalidomide/rituximab as a potential new standard of care in patients with relapsed/refractory follicular lymphoma.

Regardless of high-risk features, brexucabtagene autoleucel demonstrated positive and durable responses in BTK-naive MCL.

For patients with relapsed/refractory large B-cell lymphoma, PFS and OS data from CD-19-directed, 4-1BB CAR T-cell Liso-cel therapy were consistent with prior results.

Subgroup analysis in a phase 3 trial show OS benefits with the ramucirumab-based regimen in female patients and those with left-sided tumors.

Final analysis data from LITESPARK-005 support belzutifan as a treatment for patients with previously treated advanced clear cell RCC.

Data from the HARMONi-2 trial support the potential superiority of frontline ivonescimab vs pembrolizumab in non–small cell lung cancer.

No patients with dMMR rectal cancer enrolled on a phase 2 study required subsequent chemotherapy or radiation following treatment with dostarlimab.

The addition of liver transplant to chemotherapy in those with colorectal cancer and liver metastases boosted overall survival.

Phase 1b data support the promising therapeutic benefit of vepdegestrant/palbociclib in ER-positive breast cancer regardless of ESR1 mutation status.

Published: February 11th 2021 | Updated:

Published: December 11th 2020 | Updated:
Published: December 11th 2021 | Updated:

Published: December 14th 2021 | Updated:

Published: January 19th 2022 | Updated:

Published: February 18th 2023 | Updated: